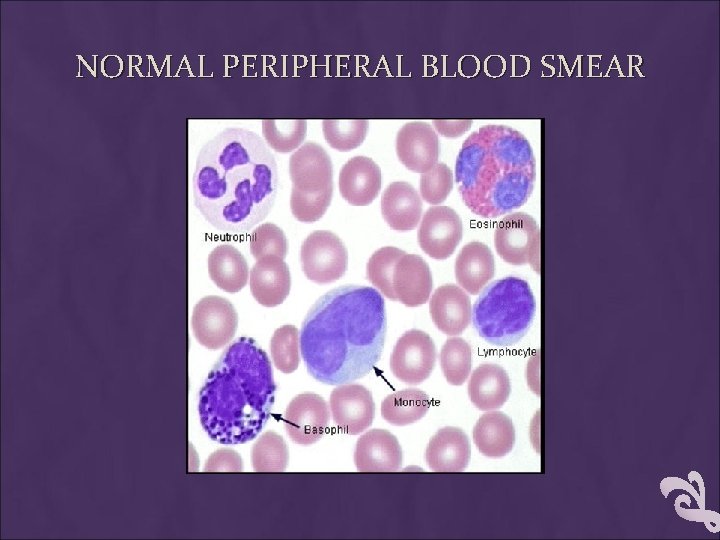
NORMAL PERIPHERAL BLOOD SMEAR
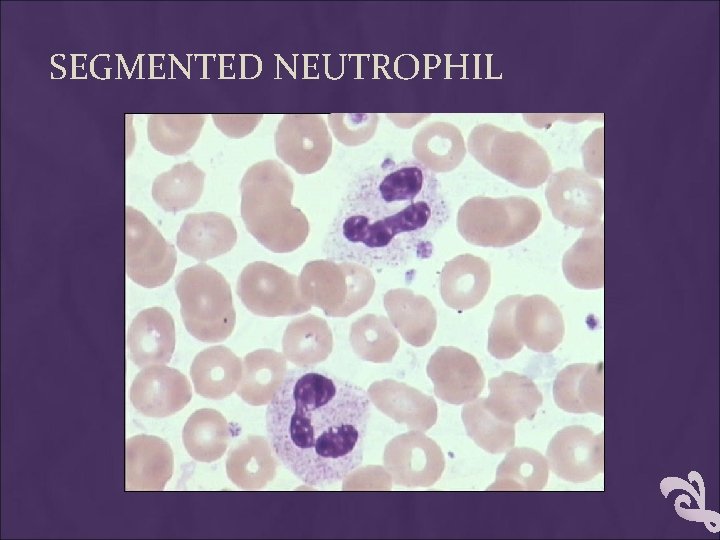
SEGMENTED NEUTROPHIL
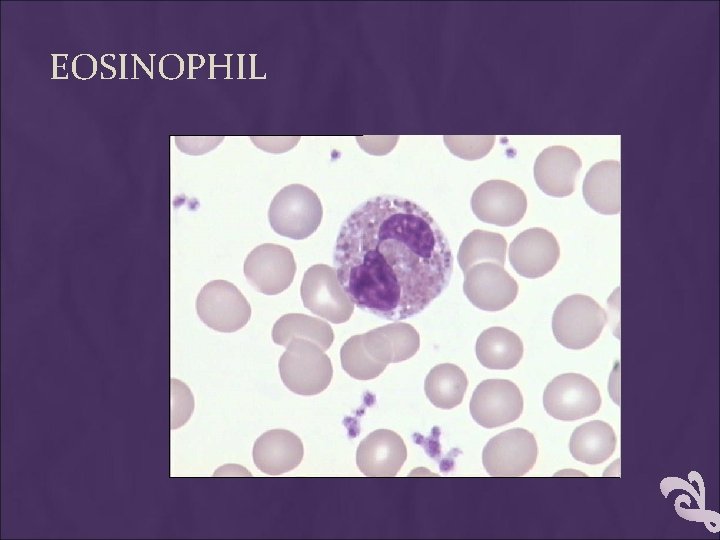
EOSINOPHIL
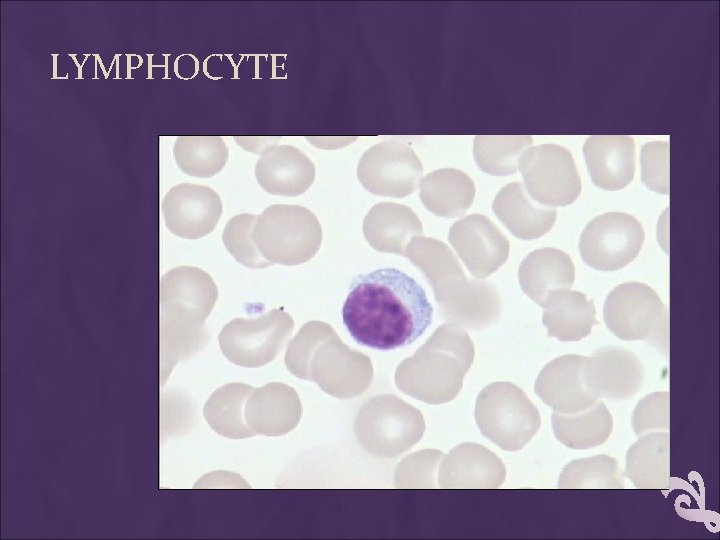
LYMPHOCYTE
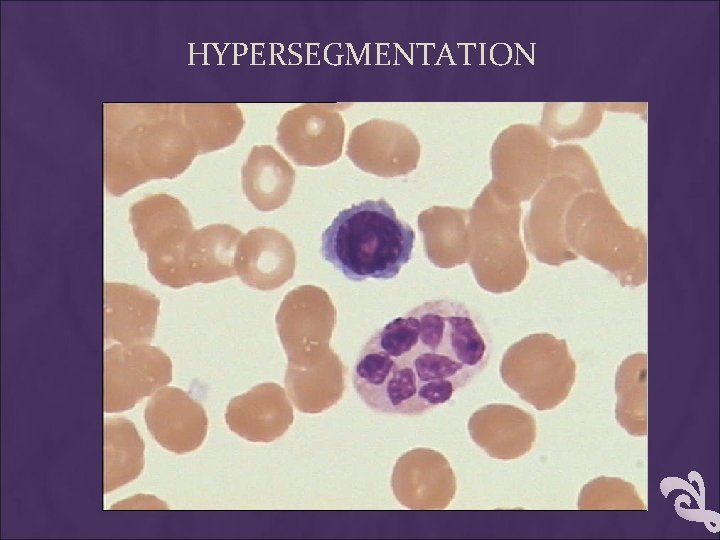
HYPERSEGMENTATION

BLOOD SMEAR EXAMINATION Making Blood smear PREPARATION OF

BLOOD SMEAR EXAMINATION Making Blood smear

PREPARATION OF BLOOD SMEAR There are three types of blood smears: 1. The cover glass smear. 2. The wedge smear. 3. The spun smear. The are two additional types of blood smear used for specific purposes 1. Buffy coat smear for WBCs < 1. 0× 109/L 2. Thick blood smears for blood parasites.

WEDGE BLOOD SMEAR Specimen : EDTA blood within 2 to 3 hours & collected to the mark on tube. Not's : May change RBCs morphology such as Spiculated (crenated) cells if : 1. Excessive amount of anticoagulant to specimen 2. Old blood - long standing. 3. Warm environment (room temperature) may hasten changes.

PROCEDURE placing a drop of blood from mixed sample on a clean glass slide. Spreader slide using another clean glass slide at 30 -40 degree angle. Control thickness of the smear by changing the angle of spreader slide Allow the blood film to air-dry completely before staining. (Do not blow to dry. The moisture from your breath will cause RBC artifact. )

high HCT small angle low HCT large angle


CHARACTERISTICS OF A GOOD SMEAR 1. Thick at one end, thinning out to a smooth rounded feather edge. 2. Should occupy 2/3 of the total slide area. 3. Should not touch any edge of the slide. 4. Should be margin free, except for point of application.

tail body head

MORPHOLOGIC CHANGES DUE TO AREA OF SMEAR Thin area- Spherocytes which are really "spheroidocytes" or flattened red cells. True spherocytes will be found in other (Good) areas of smear. Thick area - Rouleaux, which is normal in such areas. Confirm by examining thin areas. If true rouleaux, two-three RBC's will stick together in a "stack of coins" fashion. .

COMMON CAUSES OF A POOR BLOOD SMEAR 1. Drop of blood too large or too small. 2. Spreader slide pushed across the slide in a jerky manner. 3. Failure to keep the entire edge of the spreader slide against the slide while making the smear. 4. Failure to keep the spreader slide at a 30° angle with the slide. 5. Failure to push the spreader slide completely across the slide. 6. Irregular spread with ridges and long tail: Edge of spreader dirty or chipped; dusty slide 7. Holes in film: Slide contaminated with fat or grease 8. Cellular degenerative changes: delay in fixing, inadequate fixing time or methanol contaminated with water.

BIOLOGIC CAUSES OF A POOR SMEAR 1. Cold agglutinin - RBCs will clump together. Warm the blood at 37° C for 5 minutes, and then remake the smear. 2. Lipemia - holes will appear in the smear. There is nothing you can do to correct this. 3. Rouleaux - RBC’s will form into stacks resembling coins. There is nothing you can do to correct this

SLIDE FIXATION & STAINING LEISHMAN'S STAIN

PRINCIPLE LIKE ROMANOWSKY PRINCIPLE Leishman's stain : a polychromatic stain Methanol : fixes cells to slide methylene blue stains RNA, DNA === blue-grey color Eosin stains hemoglobin, eosin granules === orange-red color p. H value of phosphate buffer is very important

STAINING PROCEDURE Thin smear are air dried. Flood the smear with stain. Stain for 1 -5 min. Experience will indicate the optimum time. Add an equal amount of buffer solution and mix the stain by blowing an eddy in the fluid. Leave the mixture on the slide for 10 -15 min. Wash off by running water directly to the centre of the slide to prevent a residue of precipitated stain. Stand slide on end, and let dry in air.

TOO ACIDIC SUITABLE TOO BASIC

CAUSES & CORRECTION Too Acid Stain: 1. insufficient staining time 2. prolonged buffering or washing 3. old stain Correction: 1) lengthen staining time 2) check stain and buffer p. H 3) shorten buffering or wash time

1. Too Alkaline Stain: thick blood smear 2. 3. prolonged staining insufficient washing 4. alkaline p. H of stain components Correction : 1) 2) check p. H shorten stain time 3) prolong buffering time

PERFORMING A MANUAL DIFFERENTIAL AND ASSESSING RBC MORPHOLOGY

PRINCIPLE White Blood Cells. 1. Check for even distribution and estimate the number present (also, look for any gross abnormalities present on the smear). 2. Perform the differential count. 3. Examine for morphologic abnormalities.

PRINCIPLE Red Blood Cells, Examine for : 1. Size and shape. 2. Relative hemoglobin content. 3. Polychromatophilia. 4. Inclusions. 5. Rouleaux formation or agglutination

PRINCIPLE Platelets. 1. Estimate number present. 2. Examine for morphologic abnormalities.

PROCEDURES Observations Under × 10 1. Check to see if there are good counting areas available free of ragged edges and cell clumps. 2. Check the WBC distribution over the smear. 3. Check that the slide is properly stained. 4. Check for the presence of large platelets, platelet clumps, and fibrin strands.

Observing direction: Observe one field and record the number of WBC according to the different type then turn to another field in the snake-liked direction *avoid repeat or miss some cells

OBSERVATIONS UNDER× 40 X : WBC ESTIMATES Using the × 40 high dry with no oil. Choose a portion of the peripheral smear where there is only slight overlapping of the RBCs. Count 10 fields, take the total number of white cells and divide by 10. To do a WBC estimate by taking the average number of white cells and multiplying by 2000.

OBSERVATIONS UNDER × 100: PLATELET ESTIMATES 1. Use the oil immersion lens estimate the number of platelets per field. 2. Look at 5 -6 fields and take an average. 3. Multiply the average by 20, 000. 4. Note any macroplatelets. Platelets per oil immersion field (OIF) 1) <8 platelets/OIF = decreased 2) 8 to 20 platelets/OIF = adequate 3) >20 platelets/OIF = increased

EVALUATE WBC MORPHOLOGY Note if any abnormal white cell morphology is present o Hypersegmented poly's (5 or more lobes) o Vacuolation of neutrophils o Toxic granulation of neutrophils o Dohle bodies o Atypical Lymphocytes o Smudge cells

MANUAL DIFFERENTIAL COUNTS These counts are done in the same area as WBC and platelet estimates with the red cells barely touching. This takes place under × 100 (oil) using the zigzag method. Count 100 WBCs including all cell lines from immature to mature. Reporting results Absolute number of cells/µl = % of cell type in differential x white cell count

OBSERVING AND RECORDING NUCLEATED RED BLOOD CELLS (NRBCS) If 10 or more nucleated RBC's (NRBC) are seen, correct the White Count using this formula: Corrected WBC Count = WBC x 100/( NRBC + 100) Example : If WBC = 5000 and 10 NRBCs have been counted Then 5, 000× 100/110 = 4545. 50 The corrected white count is 4545. 50.

TIPS ON DIFF'S Do not count cells that are disintegrating • smudge cells • eosinophil with no cytoplasmic membrane and with scattered granules • Pyknotic cell (nucleus extremely condensed and degenerated, lobes condensed into small, round clumps with no filaments interconnecting). • Basket cells

ABNORMAL DIFFERENTIALS 1. 200 Cell diff: a. WBC > 15. 0 (>20. 0 for babies under 1 month and labor unit) b. Three or more basophils seen. 2. If more than five immature WBC's are seen (or any blasts) let someone else diff slide and average results. 3. Correct WBC for NRBC's if you seen ten or more NRBCs/100 WBC. 4. Always indicate number of cells counted on diff. 5. If any cell type is extremely elevated (such as bands, monos, or eos > 20) indicate that you are aware of the abnormality by circling or checking on the card next to the results.

RECORDING RBC MORPHOLOGY 1. Scan area using × 100 (oil immersion). 2. Observe 10 fields. 3. Red cells are observed for size, shape, hemoglobin content, and the presence or absence of inclusions. 4. Abnormal morphology: Red cell morphology is assessed according to See the following sample grading system. Note that red cell morphology must be scanned in a good counting area. Two questions should be asked 1. Is the morphology seen in every field? 2. Is the morphology pathologic and not artificially induced? Table 1 & 2 represents a system derived to determine a quantitative scale.

RED BLOOD CELL MORPHOLOGY A normal red blood cell should be approximately the same size as a normal lymphocyte nucleus or 2 normal sized red blood cells should fit side by side across a normal sized poly (not a hypersegmented poly). NO. of Field/ Oil imm. Grade Degree of abnormality 1 -6 per oil imm. field 1+ 7 -10 per OIF 2+ 11 -20 per OIF 3+ > 20 per OIF 4+

REPORTING RESULTS Where possible use macrocytic and microcytic, rather than simply anisocytosis alone, when describing red cell morphology. Use specific cell morphology when possible, rather than simply reporting poikilocytosis. When red cells are normocytic, normochromic, report out as NORMAL. When abnormal morphology has been noted, DO NOT indicate normal on the report form. EXAMPLE: 7 -10 microcytic RBC's/OIF is reported out as: 2+ microcytosis or Moderate microcytosis.

DETERMINE A QUANTITATIVE SCALE 1

GRADING INCLUSIONS 2

MORPHOLOGY OF WBC IN PERIPHERAL BLOOD Normal
NORMAL PERIPHERAL BLOOD SMEAR


STAB NEUTROPHIL § Diameter: 12 -16 § Cytoplasm : pink § Granules: primary secondary § Nucleus: dark purple blue § dense chromatin

BAND NEUTROPHIL

SEGMENTED NEUTROPHIL § Diameter: 12 -16 § Cytoplasm : pink § Granules: primary secondary § Nucleus: dark purple blue dense chromatin 2 -5 lobes
SEGMENTED NEUTROPHIL

EOSINOPHIL § Diameter: 14 -16 § Cytoplasm : full of granules § Granules: large refractile, orange-red § Nucleus: blue dense chromatin 2 lobes like a pair of glass
EOSINOPHIL

BASOPHIL § Diameter: 14 -16 § Cytoplasm : pink § Granules: dark blue –black obscure nucleus § Nucleus: blue

BASOPHIL

LYMPHOCYTE § Diameter: small 7 -9 large 12 -16 § Cytoplasm: medium blue § Granules: small agranular large a few primary granules § Nucleus: dark blue round dense chromatin
LYMPHOCYTE

MONOCYTE § Diameter: 14 -20 § Cytoplasm : grey blue § Granules: dust-like lilac color granules § Nucleus: blue large irregularly shaped and folded

MONOCYTE

ABNORMAL CHANGES OF WBC MORPHOLOGY

LEFT-SHIFT AND RIGHT-SHIFT OF NEUTROPHIL: Left-shift: non-segmented neutrophil > 5% Right-shift: hypersegmented neutrophil >3%

TOXIC GRANULATION

AUER BODIES(AUER ROD)
HYPERSEGMENTATION

Anisocytosis of neutrophil

vacuolization

Degeneration of nucleus

Dohle body
- Slides: 59